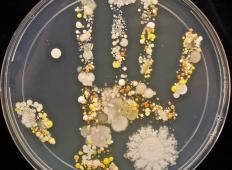

V ŽIVO!
Dékány Zdravo,
Imamo certifikat za ponudbo naslednjih vrst posojil ali katere koli vrste financiranja: Zasebno posojilo? Poslovna posojila? Posojilo za konsolidacijo dolga? Izboljšati svoj dom? Naložbeno posojilo? Na voljo krediti? Osebna posojila? Komercialna posojila? Kombinirano posojilo? Konsolidacijska posojila? Če ste zainteresirani, nas kontaktirajte: (dakany.endre@gmail.com)
Nujna posojilna ponudba.
Dékány Potrebujete posojilo??? Za več podrobnosti se prijavite za 2-odstotno obrestno mero: (dakany.endre@gmail.com).
Ponudba za nujno posojilo.
Hilda Rosales Bărbatul meu a început să iasă cu alte fete și să-mi arate dragoste rece, în mai multe rânduri amenință că se va despărți de mine dacă îndrăznesc să-l întreb despre aventura lui cu alte fete, am fost total devastată și confuză până când un vechi prieten de-al meu a spus despre un vrăjitor de pe internet, Dr Ilekhojie, care îi ajută pe oameni cu relația și problema căsătoriei prin puterile iubirii și reconcilierii Vrăji, la început m-am îndoit dacă așa ceva există vreodată, dar am decis să încerc, Când îl contactez, mi-a spus tot ce trebuia să fac și am făcut și m-a ajutat să fac o vrajă de reconciliere și în 28 de ore iubitul meu s-a întors la mine și a început să-și ceară scuze, acum a încetat să iasă cu fetele și este cu mine definitiv. Iată contactele lui Whatsapp (+2348147400259 E-mail: gethelp05@gmail.com
Carmen Doru Carmen Doru este numele meu..V-aș spune cu plăcere tuturor că am reușit să pun capăt problemei cu divorțul și să-mi restabilim căsnicia. Nu știu ce s-a întâmplat cu soțul meu că a cerut divorțul, am încercat să-l conving să nu facă asta, dar nu m-a ascultat, nu aveam altă opțiune decât să caut ajutor oriunde mă puteam gândi. de și a mers până la lungimea de a contacta DR Ibinoba și acum mă bucur că am cerut ajutor de la el. Dacă nu ar fi fost ajutorul doctorului Ibinoba, nu știu ce s-ar fi întâmplat cu căsnicia mea, pentru că îmi iubeam soțul și nu suportam să-l pierd. Vraja a funcționat ca prin magie, soțul meu s-a schimbat și a început să arate dragoste în loc de divorțul pe care îl plănuia. Sunt prea fericit că totul este la locul meu acum. Aș recomanda cu plăcere Dr. Ibinoba oricărei persoane care trec prin probleme de căsătorie și doresc să pună capăt. Dacă aveți nevoie de ajutorul unui vrăjitor autentic în orice fel de situație, contactați Dr Ibinoba pe WhatsApp: +2348085240869, E-mail: dromionoba12@gmail.com.. Cred că nu vă va dezamăgi.
Dékány Zdravo,
Imamo certifikat za ponudbo naslednjih vrst posojil ali katere koli vrste financiranja: Zasebno posojilo? Poslovna posojila? Posojilo za konsolidacijo dolga? Izboljšati svoj dom? Naložbeno posojilo? Na voljo krediti? Osebna posojila? Komercialna posojila? Kombinirano posojilo? Konsolidacijska posojila? Če ste zainteresirani, nas kontaktirajte: (dakany.endre@gmail.com)
Nujna posojilna ponudba.
Janet Rogers Soțul meu tocmai s-a trezit și a decis că căsătoria noastră s-a încheiat. De câteva luni, Roger și cu mine nu mergem bine pentru că avea o aventură cu asistentul său la serviciu. Mi-am iubit atât de mult soțul și am decis să rămân și să lucrez la căsnicia noastră. În scurt timp, Roger a încetat să mai vină acasă și prietenul lui apropiat mi-a spus că are un alt apartament în care locuiește cu ea. Am fost rănită și am continuat să caut ajutor pentru că Roger era diferit de bărbatul cu care m-am căsătorit acum 10 ani. Din fericire, l-am găsit pe doctorul Ilekhojie care mi-a promis că-mi va întoarce soțul înapoi. A făcut o vrajă de reconciliere care l-a întors pe Rogers înapoi și acum suntem amândoi din nou fericiți cu băieții noștri. Dacă aveți probleme ca ale mele, trimiteți-i un e-mail Dr. Ilekhojie: gethelp05@gmail.com sau trimiteți-i un mesaj prin Whatsapp +2348147400259
jan ihnatik Iščete zakonito nebančno posojilo? Izkoristite to odlično ponudbo finančnega posojila, ki ga je mogoče določiti za do 360 mesecev z možnostjo predčasnega odplačila brez podaljšanja 50.000 CKZ 2.900.000 CKZ. Izplačilo celotnega zneska posojila, vključno z dvigom gotovine, v 24 urah. Obljubljamo strokovno in hitro svetovanje. Popolna seznanjenost s pogoji ponudbe je seveda problem. Več informacij dobite na e-pošti: ihjan51@gmail.com
Helena Oscar Căsătoria MEA A FUNCȚIONAT DIN NOU CU AJUTORUL DR. ISIKOLO, CARE ESTE CEL MAI CEST VORAȘTOR PE CARE ÎL POȚI GĂSI
Eu sunt Helena Oscar. Casa mea a fost plină de probleme și mizerie nesfârșite care au dus la divorțul pe care nu mi l-am dorit niciodată cu soțul meu. Totul s-a prăbușit și ne-am dus pe drumuri separate. Am încercat să merg mai departe, dar mi-a fost atât de greu pentru că încă îmi iubeam soțul și fiica mea a plâns mereu dorindu-și tatăl înapoi. Nu am avut de ales decât să caut ajutor, ceea ce m-a determinat să îl contactez pe DR ISIKOLO după ce am văzut atât de multe remarci bune despre munca lui. M-a asigurat că mă împac pe mine și pe soțul meu cu vraja lui de reconciliere pe care a făcut-o. Mă bucur să vă spun tuturor că dragostea și fericirea au fost restabilite și ne-am revenit împreună și cred că va fi pentru totdeauna pentru noi și toate mulțumim lui DR ISIKOLO pentru că a făcut atât de mult pentru a-mi salva familia. Nu este niciodată prea ocupat să ajute pe cineva. Așa că contactează-l acum dacă și tu ai nevoie de ajutor. e-mail-i acum prin: isikolosolutionhome@gmail.com sau pur și simplu trimite-i prin WhatsApp/Telegram: +2348133261196